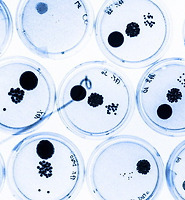

스마트맨의원
유레아플라즈마 남자 증상과 치료 방법은? 본문
안녕하십니까?
스마트맨의원 입니다.
오늘은 유레아플라즈마 증상과 치료에 대하여 알아보는 시간을
갖도록 하겠습니다.
많은 분들에게는 유레아플라즈마 라는 것이 생소한 증상이 아닐까
싶습니다.
- 유레아플라즈마 란?
보통의 경우, 성접촉으로 인하여 전파가 되지만, 여성의 경우에는
성접촉이 아니더라도 감염이 될 수 있습니다.
비임균성 요도염의 하나로써, 임균성 요도염에 비해 증상이 적은
경우가 많습니다.
그냥 두는 경우도 있으나, 여성에게 골반염을 유발할 수 있습니다.
- 유레아플라즈마 증상
혈뇨 또는 배뇨시 통증과 요도에 하얀 분비물이 나오는 등의 증상
을 겪을 수 있으며, 이 증상을 겪게 되는 것은 남성 보다는 여성이
증상을 많이 보이게 됩니다.
- 감염 경로
단순한 성접촉에서만 전염이 되지 않습니다.
목욕탕이나 청결하지 않은 화장실에서도 전염이 되는 경우도
찾아 볼 수 있습니다.
- 유레아플라즈마 남자에게도 증상이?
남성에게는 요도염 도는 전립선염의 합병증을 유발시킬 수 있으며,
여성에게는 골반염 또는 질염 등의 훨씬 치명적인 합병증을 유발
할 수 있습니다.
불임의 원인이 되기도 하지만, 극히 드문 경우이긴 하지만 유레아
플라즈마가 변형되어 난치성 유레아플라즈마로 변형이 될 수 있는
확률도 존재 합니다.
- 치료 어떻게 할까?
성병검진을 진행 하여 PCR검사를 진행하게 됩니다.
적은양의 DNA를 다량으로 증식 시켜 성병 원인균 및 각종 바이러스
검출이 가능한 성병 원인균 정밀검사 를 통해 발견 합니다.
또한, 원인 균에 따른 항생제를 투여 해야 합니다.
성매개 감염으로 동반된 경우에는 파트너 또한 치료를 함께
받아야 합니다.
감사합니다.
'성병정보' 카테고리의 다른 글
| 헤르페스 바이러스 증상과 치료 방법은? (0) | 2016.10.27 |
|---|---|
| 성병 두드러기 왜 나타날까? (0) | 2016.10.13 |
| 청담 성병 치료 및 예방, 스마트맨의원과 함께! (0) | 2016.09.28 |
| 성병검사비용 청담동에서 알아보자 (0) | 2016.09.07 |
| 남자 매독 증상 어떻게 날까? (0) | 2016.09.05 |